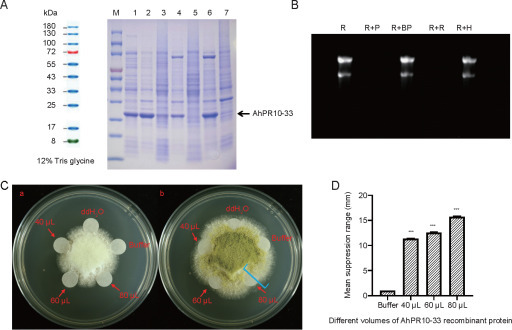

Cultivated peanut AhPR10 gene family mediates resistance to Aspergillus flavus
Published 02 February, 2026
Pathogenesis-related (PR) proteins comprise a group of proteins synthesized by plants in response to biotic and abiotic stress. In particular, the PR10 family (nuclease activity) represents the largest PR protein subfamily and plays a vital role in plant growth, development, and stress responses.
In a new study published in the Journal of Integrative Agriculture, a team of researchers from China identified and analyzed PR10 genes in cultivated peanut (Arachis hypogaea L.), examining their phylogenetic relationships, conserved motifs, gene structures, and syntenic relationships.
“The analysis identified 54 AhPR10 genes, which were classified into eight groups based on phylogenetic relationships, supported by gene structure and conserved motif characterization,” shares corresponding author Xinyou Zhang, an academician and professor at Henan Academy of Agricultural Sciences. “Analysis of chromosomal distribution and synteny demonstrated that segmental duplications played a crucial role in the expansion of the AhPR10 gene family. The identified AhPR10 genes exhibited both constitutive and inducible expression patterns.”
Notably, AhPR10-7, AhPR10-33, and AhPR10-41 demonstrated potential importance in peanut resistance to Aspergillus flavus.
“In vitro fungistatic experiments demonstrated that recombinant AhPR10-33 effectively inhibited A. flavus mycelial growth,” adds co-corresponding author Suoyi Han, a professor at Henan Academy of Agricultural Sciences. “These findings provide valuable insights for future investigations into AhPR10 functions in protecting peanut from A. flavus infection.”
Contact Authors:
Correspondence Xinyou Zhang, E-mail: haasxinyou@163.com; Suoyi Han, E-mail: suoyi_han@126.com
Funder:
This work was supported by the National Key R&D Program of China (2022YFD1200400) and the National Natural Science Foundation of China (32301851).
Conflict of Interest:
The authors declare that they have no conflict of interest.
See the Article:
Zhao Q, et al. 2026. Genome-wide characterization and expression analysis of the cultivated peanut AhPR10 gene family mediating resistance to Aspergillus flavus. Journal of Integrative Agriculture, 25(1): 56-67.